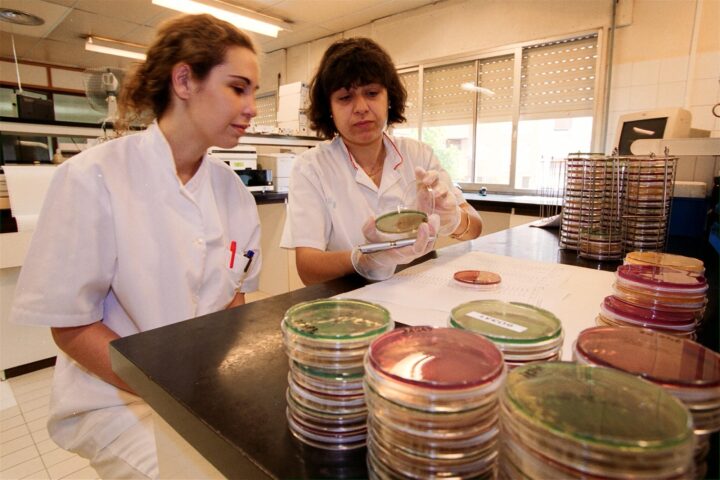
Hospital Universitari

Cronologia
Un recorregut per la història del Trueta a través de les dècades
1940-1949
Assentant les bases de la sanitat pública

Creació del “Seguro Obligatorio de Enfermedad”
Es crea el primer mecanisme de caràcter obligatori a Espanya de protecció de malalties.
El Plan Nacional de Instalaciones Sanitárias
Preveu la construcció de 67 Residències Sanitàries, 62 ambulatoris complets i 104 ambulatoris reduïts en tot l’Estat.
1950-1959
Els inicis del Trueta

Inauguració del primer ambulatori de la Seguretat Social a Girona
Ubicat a la mateixa seu de la Delegació Provincial de l’I.N.P a Girona, al carrer de les Bernardes, avui carrer Santa Clara.
Adquisició del terreny
L’Instituto Nacional de Previsión adquireix els terrenys per edificar la futura Residència Sanitària de Girona al terme de Sant Gregori per 393.423 pessetes.

Inici de la construcció de l’hospital
S’adjudica la construcció a l’empresa Huarte y Cía. L’arquitecte és Aurelio Botella, que aposta per un edifici funcional, amb capacitat inicial per a 200 llits, amb deu plantes i més de 9.000 m².

Plantilla de treballadors a l’inici de la Residència
La plantilla estava formada pel director mèdic, Fidel Rivas i Concejo, i 28 metges. El personal sanitari complementari comptava amb infermeres, matrones i ajudants d’infermeria, mentre que el personal no sanitari incloïa administratius, zeladors, subalterns, personal d’ofici i capellans.
Inici de les activitats
L’hospital entra en funcionament amb 291 llits, amb plantes dedicades a cirurgia, traumatologia, parts i ginecologia, i serveis auxiliars com laboratori, radiologia i esterilització. Les plantes superiors allotjaven la capella, residència de monges i Escola d’Infermeres, mentre que soterranis acollien cuina, magatzems i calderes.

Primera intervenció quirúrgica
El 13 d’abril de 1956, dia de la inauguració del centre, es realitzà la primera intervenció quirúrgica: una noia de 16 anys de Banyoles diagnosticada d’“apendicitis crònica”.

Inauguració oficial
El 13 d’abril de 1956, s’inaugura la “Residencia Sanitaria de la Seguridad Social de Gerona”, es converteix en la construcció més moderna i ambiciosa de la ciutat.

Denominació “Álvarez de Castro”
En ple franquisme, l’hospital adopta el nom de “Residencia Sanitaria Álvarez de Castro”, un militar espanyol de la Guerra del Francès. Aquest nom es mantindrà fins al 1990, quan es canviarà per l’actual.

1960-1969
S’obre l’Escola d’Infermeria

Creació de l’Escola d’Infermeria
Es crea l’Escola d’Infermeria dins l’hospital, ocupant la vuitena planta, per formar el seu propi personal. Amb els anys, aquesta escola es convertirà en una de les primeres institucions docents sanitàries de la demarcació.

1970-1979
Consolidació i creixement: jerarquització de serveis i UCI

Jerarquització dels serveis mèdics
L’hospital reorganitza els seus serveis i crea equips mèdics estables amb caps i metges adjunts. Aquest procés consolida les especialitats i millora la qualitat assistencial, marcant l’inici de l’etapa moderna del centre.
Primera extracció d’òrgans
Es realitzen les primeres extraccions d’òrgans per trasplantament, convertint Girona en pionera en aquesta pràctica dins la xarxa hospitalària catalana.
Naixement de la Unitat de Cures Intensives i formació MIR
S’inaugura la Unitat de Medicina Intensiva i la Unitat Coronària, i el centre és acreditat per formar metges residents. Aquest fet consolida el Trueta com a hospital docent i referent regional.

1980-1989
Modernització i ampliació

Transferència a la Generalitat de Catalunya
Amb el traspàs de competències sanitàries, l’hospital passa a dependre de la Generalitat. S’obre una nova etapa de gestió catalana que coincideix amb el 25è aniversari del centre.
Obres d’ampliació
Durant aquests anys es duen a terme importants reformes: ampliació de quiròfans, creació de reanimació postquirúrgica i millora de les instal·lacions generals. També s’hi construeix un gran aparcament per adaptar-se al creixement de la ciutat.

Noves tecnologies i especialitats
S’instal·la el primer TAC i s’introdueixen serveis punters com la Neurocirurgia, la Cirurgia Vascular i la Unitat del Dolor. El Trueta esdevé un centre d’alta complexitat per a tot el territori gironí.

Reforç de l’àrea mèdica
Es crea la Unitat de Cirurgia Pediàtrica i la Unitat Coronària. També s’obren els serveis de Nefrologia i Hemodiàlisi, que permeten tractar pacients crònics sense desplaçar-se a Barcelona.

1990-1999
Canvi de nom i projecció de futur

Canvi de nom a “Hospital Dr. Josep Trueta”
Després d’anys de reivindicacions, l’hospital abandona la denominació franquista “General Álvarez de Castro” i adopta el nom del prestigiós cirurgià català Josep Trueta, símbol de medicina i humanisme.

Hospital Olímpic
Durant els Jocs Olímpics de Barcelona, el Trueta dona suport sanitari a les proves de rem i piragüisme celebrades a Banyoles. Aquest esdeveniment impulsa millores en les instal·lacions, especialment als serveis d’urgències i quiròfans.
Fotografia de Pere Duran per la Fundació Lluís Coromina Isern.

Creació de la Fundació Dr. Josep Trueta
Es constitueix la Fundació Dr. Josep Trueta per fomentar la investigació, la docència i la col·laboració amb la Universitat de Girona.
Creació de la UFISS
S’estableix la Unitat Funcional Interdisciplinària Sociosanitària (UFISS), pionera a la demarcació. El seu objectiu és oferir atenció integral a pacients crònics o dependents, en coordinació amb els serveis socials i sanitaris de la regió.
Esdevé hospital universitari
El Trueta consolida la seva vocació docent amb el reconeixement oficial com a Hospital Universitari de Girona Doctor Josep Trueta, dins de l’Institut Català de la Salut. Aquesta distinció el vincula directament amb la Universitat de Girona, cosa que permet la formació de metges interns residents (MIR) i d’infermeres, així com l’impuls a la recerca biomèdica i a la col·laboració amb altres institucions acadèmiques i sanitàries del territori.
Fi de la comunitat religiosa
Després de 40 anys de servei ininterromput, les Filles de la Caritat de Sant Vicenç de Paül van deixar l’hospital. Aquesta congregació havia estat present des de la inauguració, el 1956, gestionant serveis essencials com la cuina, el cosidor, la infermeria i la residència d’estudiants.

Integració del Banc de Sang de Girona al CTBT
Al gener de 1997, el Banc de Sang i Teixits de l’Hospital Universitari de Girona Dr. Josep Trueta va passar a formar part del Centre de Transfusió i Banc de Teixits (CTBT), és a dir, es va integrar dins la xarxa pública de transfusió i teixits de Catalunya per treballar de manera coordinada amb la resta del sistema.
Incorporació del servei d’Oncologia
Inici de l’hospitalització oncològica a l’hospital per trasllat del Servei d’Oncologia de l’Hospital de Santa Caterina.
Incorporació de la Ressonància Magnètica i l’IDI
S’instal·la la primera màquina de ressonància magnètica i s’inicia la col·laboració amb l’Institut de Diagnòstic per la Imatge (IDI). L’hospital entra plenament a l’era del diagnòstic digital i tecnològic

2000-2009
La revolució informàtica al Trueta

Consolidació com a hospital universitari
L’Hospital Trueta reforça la seva vinculació amb la Universitat de Girona i amb la formació de professionals sanitaris. L’activitat docent i de recerca s’incrementa, i el centre comença a publicar estudis i treballs científics de referència.
Integració de l’ICO
S’incorpora l’Institut Català d’Oncologia (ICO) a l’estructura, integrant els serveis d’oncologia clínica, radioteràpia i hematologia a la xarxa hospitalària de Girona.
Reconeixement per l’OMS
L’Hospital va ser acreditat com a Hospital Promotor de la Salut i va constituir la seva Comissió Hospital Promotor de la Salut, que va impulsar iniciatives com la política “Hospital sense fum” i altres programes de promoció de la salut.
Creació de l’IDIBGI
L’antiga Agència d’Investigació de la Fundació Dr. Josep Trueta va evolucionar fins a convertir-se en l’Institut d’Investigació Biomèdica de Girona (IDIBGI), formalitzat el 2005 com a entitat de recerca de referència a les comarques gironines.

Nova unitat de cures intensives (UCI) ‘sense papers’
Entrà en funcionament la nova Unitat de Cures Intensives del Trueta, amb duplicació de superfície (600 a 1.200 m²) i 18 llits, i introducció de gestió informàtica (primera UCI ‘sense papers’ de l’Estat)

Distinció UNICEF “Hospital amic dels nens”
L’hospital rep el reconeixement internacional per promoure l’alletament matern i una atenció pediàtrica més humana. Aquesta fita consolida el compromís de l’hospital amb la salut infantil i amb una assistència centrada en les persones.
Conveni amb Xaropclown
Signatura de conveni amb Xaropclown per a la humanització de l’Hospital Trueta via pallassos hospitalaris.

Inici de la Facultat de Medicina
Inici del primer curs de la Facultat de Medicina a la Universitat de Girona, amb col·laboració del Trueta com a centre docent.

Primera obtenció de cèl·lules progenitores
El Banc de Sang i Teixits de Girona al Trueta realitza la primera obtenció de cèl·lules progenitores per a auto trasplantament.

Implantació del sistema informàtic SAP Assistencial
Implantació del sistema informàtic SAP Assistencial al Trueta, iniciant l’any de la ‘revolució informàtica’ del centre. Això implica que els processos d’atenció, indicacions, gestió de dades de pacients passaven a sistemes més integrats.

Inici de la radiologia intervencionista
Inici dels procediments de radiologia intervencionista al Trueta, amb 155 procediments registrats en el primer any.
2010-2019
Consolidació tecnològica i assistencial

Accés a Història Clínica Compartida (HCC)
Després de la implantació del SAP Assistencial l’any 2009, el Trueta va anar integrant l’accés a la Història Clínica Compartida (HCC) i a sistemes digitals d’historial electrònic en els anys següents.
Reconeixement en recerca (SCImago)
En l’estudi Scimago Institutions Rankings publicat el 2011 el Trueta va aparèixer com a un dels hospitals capdavanters a l’estat en excel·lència investigadora, concretament es va destacar que el Trueta era el segon hospital a l’Estat en termes d’un indicador d’excel·lència investigadora.
Nou edifici de consultes externes
Entra en funcionament el nou edifici ambulatori modular del Trueta amb 89 espais de consultes externes (74 consultes per a professionals de l’ICS i 15 per a l’ICO). Aquest edifici va unificar consultes externes i millorar l’organització.

Ampliació hemodinàmica 12 hores
Durant 2012 es va ampliar l’horari de la unitat d’hemodinàmica fent-la funcionar 12 hores al dia, amb la finalitat de millorar resultats del Codi Infart. Posteriorment, es va estendre a 24 h el 2015.
Graduació primera promoció de metges UdG
La primera promoció del grau en Medicina de la Universitat de Girona (curs inici 2008-09) es va graduar el juny de 2014; aquests metges s’havien format amb rotacions i activitats docents al Trueta (paper com a centre docent).

Noves urgències de pediatria
Es posen en funcionament les noves urgències pediàtriques, renovant espais i organització per atendre el volum de consultes pediàtriques del centre i de la regió.

Reforma del espais del Banc de Sang i Teixits al Trueta
Es duu a terme la primera gran obra als espais: nova sala de donació més amable, amb llum natural, i reorganització dels laboratoris i àrees de treball.

Incorporació del robot quirúrgic (Da Vinci)
El 10 d’abril de 2018 es va realitzar la primera intervenció amb cirurgia robòtica al Trueta (Da Vinci). Inicialment, el programa va començar en urologia (pròstata i cirurgia renal) i en setmanes posteriors es van incorporar ginecologia i cirurgia colorectal. El Trueta va ser el primer hospital de la Regió Sanitària de Girona en incorporar cirurgia robòtica pública.

Cirurgia amb pacient despert (mapatge cerebral)
L’equip de Neurocirurgia del Trueta va començar a fer cirurgia de mapatge cortical “awake craniotomy” per extreure tumors situats en zones implicades en llenguatge o motricitat, utilitzant tècniques de neuro-monitoratge i mapa funcional per reduir dèficits.

2020-2029
La IA arriba al Trueta

Impacte de la COVID-19 i reorganització assistencial
El 2020, el Trueta es va reorganitzar completament per afrontar la COVID-19: va crear circuits diferenciats, ampliar llits crítics i adaptar quiròfans per mantenir l’activitat essencial. També va impulsar l’hospitalització domiciliària i les consultes telemàtiques, assegurant l’atenció continuada en plena pandèmia.

Radiologia vascular intervencionista 24 h
L’hospital amplia a les 24 hores del dia la guàrdia de radiologia vascular intervencionista destinada als tractaments urgents. Amb aquesta acció es cobreix la franja nocturna, s’actuarà amb més rapidesa davant de les urgències i es preveu que cada any s’estalviarà el trasllat d’un centenar de pacients a altres hospitals de Barcelona

Nova àrea de Radiologia Intervencionista
El Trueta destina més de 3 milions d’euros per crear una nova àrea de radiologia intervencionista a la planta baixa de l’hospital, amb tres sales específiques (diagnòstic per la imatge, neurointervencionisme, procediments vasculars).

Unitat de paràlisi cerebral infantil
L’Hospital Trueta va posar en funcionament la nova Unitat Funcional de Paràlisi Cerebral infantil, concebuda com un servei multidisciplinari integrat que reuneix neuropediatria, rehabilitació i traumatologia.

Laboratori de reproducció humana assistida
El Trueta estrena un laboratori de reproducció humana assistida de darrera generació: fertilització in vitro, criobiologia, andrologia i més sota un mateix sostre.

Posada en marxa de la Unitat d’Hospitalització a Domicili
El Trueta inaugura la unitat d’hospitalització a domicili, una modalitat assistencial que permet que pacients adults estables, procedents d’Urgències, siguin ingressats però tractats des de casa seva amb cobertura hospitalària 24 h.

Millora de la planta de Ginecologia i Obstetrícia
Millora de la planta de Ginecologia i Obstetrícia amb la posada en funcionament de 16 habitacions (14 d’individuals i 2 de dobles) completament reformades i amb tot el necessari per tenir cura del nadó dins el mateix espai, sense que hagi de deixar l’estança, si no és per qüestions clíniques.

Farmàcia amb certificació Q-PEX
El Servei de Farmàcia Hospitalària del Trueta va rebre la certificació Q-PEX de qualitat i excel·lència en l’atenció al pacient extern, atorgada per la Sociedad Española de Farmacia Hospitalaria (SEFH). Aquest reconeixement el converteix en el primer hospital de Catalunya a obtenir aquest segell en la seva categoria.

Laboratori de genòmica
Medicina personalitzada amb tècniques genètiques avançades.

Parts a l’aigua
Incorporació de banyera d’hidroteràpia per a gestants.

Teràpia amb gossos
Suport emocional a infants amb paràlisi cerebral.

La IA revoluciona els procediments
Intel·ligència artificial per optimitzar les admissions a urgències: sistema basat en xarxes neuronals que anticipa les admissions hospitalàries. D’aquesta manera, es facilita la gestió del flux de pacients.

Nou centre de Simulació Clínica
El Trueta inaugura un Centre de Simulació Clínica pioner a la Regió Sanitària Girona per formar professionals sanitaris en un entorn segur i realista.

Laboratori de genòmica i medicina personalitzada
El Trueta posa en marxa un laboratori de genètica i biologia molecular de més de 400 m² al Parc Hospitalari Martí i Julià. Permet fer proves de seqüenciació genètica avançada per adaptar els tractaments al perfil genètic de cada pacient.

Més per descobrir







